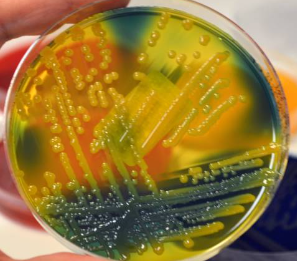

국, 찌개, 볶음, 무침... 대파 없는 한식은 상상할 수 없습니다. 우리는 대파를 사서 냉장고에 보관하며 며칠, 혹은 몇 주에 걸쳐 사용합니다.

그런데 며칠 뒤, 썰기 위해 꺼낸 대파에서 '끈적한 진액'이 나오는 것을 발견한 적 없으신가요?
우리는 40년간 이것을 그저 대파의 '신선한 즙'이거나, '원래 나오는 것'이라며 무심코 씻어서 요리해 먹었습니다. "어쩐지 배탈이 났다"고 생각하면서도, 그 원인이 대파일 줄은 상상도 못 했죠.
하지만 이 '끈적한 진액'의 정체는... 사실 1g에 식중독균 100만 마리가 득실대는 '세균 덩어리'입니다.
1. 그것은 '즙'이 아니라 세균의 '뷔페'입니다
대파를 자른 '단면'은 세균에게는 문이 활짝 열린 '최고급 뷔페'입니다.
대파의 풍부한 '수분'과 '당분'은 식중독균이 번식하기에 완벽한 영양분입니다. 특히 냉장고에 보관하는 동안, 대파의 잘린 단면에서는 이 영양분들이 밖으로 새어 나옵니다.
냉장고 속을 떠돌던 각종 세균(리스테리아, 황색포도상구균 등)이 이 뷔페에 달라붙어, 하룻밤 만에 수백만 마리로 증식합니다.
2. '끈적한 진액'은 세균의 '보호막'입니다

우리가 발견한 그 '끈적한 진액'은 대파의 즙이 아닙니다. 그것은 세균들이 스스로를 보호하기 위해 만들어낸 '바이오필름(Biofilm)'이라는 끈적한 보호막입니다.
세균들은 이 '진액'이라는 집 안에 숨어, 항생제나 세척제로부터 스스로를 방어합니다. 이 끈적한 점액질 1g 속에는 무려 100만 마리 이상의 식중독균이 득실대고 있습니다.
3. 40, 50대의 '장(腸)'을 '썩게' 만듭니다

젊을 때는 이겨낼지 모릅니다. 하지만 40대, 50대부터는 이야기가 다릅니다.
면역력이 떨어지고 위산 분비가 줄어든 40, 50대의 장(腸)에, 이 '세균 덩어리'가 그대로 유입되면 어떻게 될까요? 장벽은 쉽게 뚫리고, 이 세균들은 '만성 염증'을 유발합니다.
"어쩐지 배가 더부룩하고 가스가 찼다", "이유 없이 설사와 변비를 반복했다"면, 바로 이 '대파 진액' 속 세균들이 당신의 장을 '썩게' 만들고 있었을지도 모릅니다.
4. '씻거나 끓여도' 절대 안전하지 않습니다

가장 큰 문제는 '씻어도' 소용없다는 것입니다. 끈적한 '바이오필름'은 물로 헹구는 정도로는 절대 제거되지 않습니다.
"그럼 끓여 먹으면 괜찮지 않나?"
이것이 가장 치명적인 착각입니다. 끓이면 세균은 죽을지 몰라도, 세균이 이미 뿜어낸 '독소(Enterotoxin)'는 열에 파괴되지 않습니다. 끓이면 끓일수록 독소는 국물에 진하게 우러나올 뿐입니다.
오늘부터 냉장고 속 대파를 확인해 보세요. 만약 칼을 댔을 때 '끈적한 진액'이 묻어 나온다면, 그것은 '신선함'이 아니라 '부패'의 신호입니다.
1초도 망설이지 말고 '당장 버리세요'. 그 몇백 원 아끼려다, 식중독은 물론 '위암'과 '대장염'의 원인이 되는 '세균 덩어리'를 섭취할 수는 없습니다.
Copyright © 저작권법에 따라 허락 없이 무단 복제, 배포, 전재를 금지합니다.